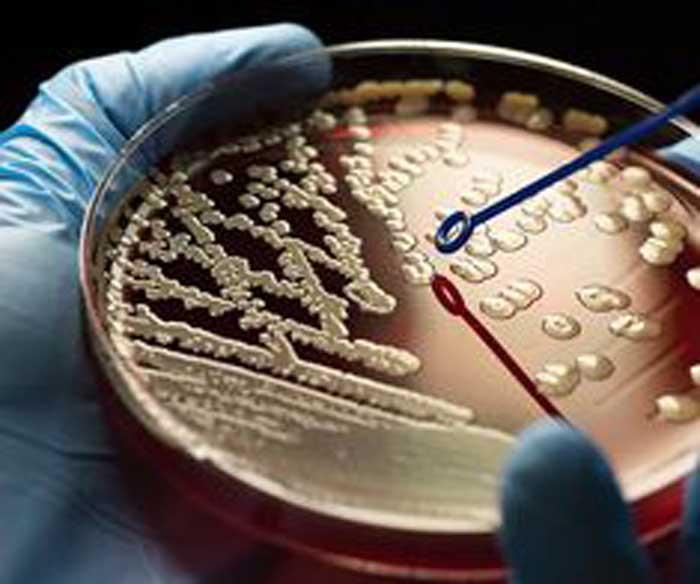

Antibiotics: Are We Creating Stronger Bacteria?

By Dewmi Dodhani
There was a time when antibiotics felt almost like a miracle of modern medicine. Infections that once led to serious complications or death could suddenly be treated with a simple course of medication. A sore throat, an infected wound, or a persistent fever could be resolved quickly and effectively. For many people, antibiotics became a symbol of medical progress, something dependable and powerful that could be trusted without hesitation. They transformed healthcare and reshaped expectations about illness and recovery. Over time, however, that sense of complete trust has begun to shift. The medications themselves have not lost their original purpose or design. Instead, the organisms they are meant to control have changed. Bacteria, which antibiotics were created to eliminate, are proving to be far more adaptable than once imagined. This growing adaptability is now challenging the effectiveness of treatments that were once considered routine.
Antibiotic resistance is no longer an abstract idea discussed only in scientific communities. It is a real and present issue that is unfolding quietly in everyday life. Many people may not notice it directly, but its effects are becoming more widespread. What makes this situation especially concerning is that human behaviour plays a significant role in accelerating it. At its most basic level, antibiotic resistance is a clear demonstration of evolution. Bacteria are living organisms that can respond to their environment in order to survive. When antibiotics are introduced, they are designed to kill harmful bacteria causing an infection. In many cases, they succeed in eliminating a large portion of these organisms. However, not every bacterium is identical. Some may carry natural variations that allow them to survive exposure to the drug.
These surviving bacteria continue to multiply, passing on the traits that helped them endure. As this process repeats, the population gradually shifts. Over time, more and more bacteria become resistant to the antibiotic that once eliminated them easily. What was once an effective treatment becomes less reliable, and in some cases, ineffective altogether. While this process is rooted in biology, it is strongly influenced by how antibiotics are used. The way people interact with these medications can either slow down or accelerate the development of resistance. Unfortunately, antibiotics are often used in ways that unintentionally encourage stronger bacteria to emerge.
One common issue is the use of antibiotics for illnesses they cannot treat. Viral infections such as colds or influenza do not respond to antibiotics, yet these medications are sometimes taken in the hope of speeding up recovery. This unnecessary exposure gives bacteria more opportunities to adapt without providing any real benefit to the patient. Another contributing factor is the tendency to stop taking antibiotics once symptoms improve. When a person begins to feel better, it can seem unnecessary to continue the medication. However, stopping early may leave behind bacteria that were not completely eliminated. These remaining bacteria are often the ones that are more resilient, and they can multiply, leading to infections that are harder to treat in the future.
There are also instances where antibiotics are used without proper medical guidance. This may include taking leftover medication or obtaining antibiotics without a prescription. In such cases, the dosage or duration may not be appropriate, further increasing the likelihood that bacteria will survive and adapt.

Individually, these actions might appear insignificant. However, when they occur across large populations, their impact becomes substantial. Each instance of misuse creates an opportunity for resistant bacteria to develop and spread. The spread of resistant bacteria is another aspect that makes this issue particularly serious. These organisms do not remain confined to a single individual. They can be transmitted from person to person, through direct contact, shared environments, or even through food and water. Communities can become affected, and resistance can travel across regions and countries.
Healthcare settings are especially vulnerable to this problem. Hospitals often use antibiotics frequently, which creates an environment where resistant bacteria can thrive. Patients in these settings may already have weakened immune systems, making them more susceptible to infections. When those infections are resistant to standard treatments, they become much more difficult to manage. The implications of antibiotic resistance extend far beyond treating everyday infections. Many aspects of modern medicine depend on the ability to control bacterial infections effectively. Surgical procedures, cancer therapies, and organ transplants all rely on antibiotics to prevent or treat infections that could otherwise become life threatening.
If antibiotics lose their effectiveness, these procedures become significantly riskier. What is currently considered routine could become dangerous. In this sense, antibiotic resistance threatens not just individual treatments but the broader foundation of healthcare as it exists today. Despite its importance, antibiotic resistance often remains out of sight for the general public. Unlike sudden outbreaks or highly visible diseases, it develops gradually. There is no single moment when the problem becomes obvious. Instead, it appears in subtle ways. An infection may take longer to heal. A doctor may need to switch medications. Stronger drugs may become necessary to achieve the same results.
This gradual progression can make it difficult for people to recognize the seriousness of the issue. Without clear and immediate consequences, it is easy to underestimate the long-term impact of everyday choices related to antibiotic use. Awareness plays a crucial role in addressing this challenge. Many people still view antibiotics as a quick and simple solution to illness. The idea that using them improperly today can affect treatment options in the future is not always considered. Changing this mindset is an important step toward reducing the spread of resistance.
Fortunately, meaningful change does not require complex or unrealistic actions. It begins with simple and consistent habits. Taking antibiotics only when they are prescribed by a qualified healthcare professional is essential. Following the prescribed dosage and completing the full course of treatment helps ensure that infections are properly eliminated. Recognizing that not all illnesses require medication can also reduce unnecessary use. These actions may seem basic, but their collective impact is significant. When practiced consistently, they can slow the development of resistance and preserve the effectiveness of existing treatments.
Healthcare systems also have an important role to play. Improving prescription practices can help ensure that antibiotics are used appropriately. Strengthening infection control measures can reduce the spread of resistant bacteria in medical settings. Continued research is necessary to develop new treatments and better understand how resistance evolves.
However, the development of new antibiotics alone is not a complete solution. Bacteria have consistently demonstrated their ability to adapt. If patterns of misuse continue, resistance will eventually emerge even against newly developed drugs. This makes responsible use just as important as innovation. In response to these challenges, researchers are exploring alternative approaches to managing bacterial infections. One area of interest is bacteriophage therapy, which uses viruses that specifically target bacteria. Another approach focuses on interfering with bacterial behaviour rather than killing them directly. These strategies represent a shift in thinking, moving from simply eliminating bacteria to managing how they function and evolve.
Such developments highlight the need for a more balanced relationship with the microbial world. Not all bacteria are harmful, and understanding their role within the human body is an important part of developing sustainable treatments. Ultimately, antibiotic resistance is not just a scientific or medical issue. It is a shared responsibility that involves individuals, healthcare providers, and society as a whole. It reflects the interaction between human behaviour and biological processes. Small decisions made in everyday life can have far reaching consequences over time. The way antibiotics are used today will influence how effective they remain in the future. This places a level of responsibility on everyone who has access to these medications. Each choice contributes to a larger pattern that shapes the evolution of bacteria.
We are not simply using antibiotics as tools for treatment. We are actively influencing the environment in which bacteria evolve. This means that the future effectiveness of these drugs depends not only on scientific advancement but also on human behaviour. The question is no longer whether bacteria will adapt. Their ability to do so is already well established. Resistance is developing, and in some cases, it is spreading rapidly.
The more pressing question is whether we are willing to change how we use antibiotics before their effectiveness declines further. The outcome will depend on the choices made today, both individually and collectively. Antibiotics remain one of the most valuable resources in modern medicine. Preserving their effectiveness requires awareness, responsibility, and a willingness to adapt our own behaviour. Without these changes, the very tools that once transformed healthcare could lose their power, leaving future generations with fewer options to treat infections that are currently manageable.
